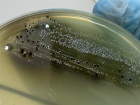
В Астраханской области готовили к продаже кур с очень опасными бактериями

лед Новости Блокнот-Астрахани
-
Под Астраханью женщина придумала преступление, которого не было 16.04.2026 Происшествия -
В Астраханской области готовили к продаже кур с очень опасными бактериями 03.04.2026 Общество -
В Астраханской области женщина безжалостно вонзила нож в сердце любимого 02.04.2026 Происшествия -
В Астраханской области пьяный мужчина избил полицейского 23.03.2026 Происшествия -
Названивал и караулил у дома: астраханца задержали за преследование девочки 21.03.2026 Общество -
Крепкий лед помешал началу путины в Астраханской области 18.03.2026 Общество -
В астраханском селе состоялась тренировка по ликвидации последствий затопления 12.03.2026 Общество -
В Астраханской области утонул мальчик, провалившись под лед 06.03.2026 Происшествия -
В Астраханской области контрольные уловы воблы упали до 1% 04.03.2026 Животный мир -
Разводили костер и гуляли рядом: в Астрахани спасатели уводили детей со льда 04.03.2026 Общество -
Астраханское УМВД ищет толковых следователей и полицейских 03.03.2026 Общество -
В Астраханском кремле завершилась «Зимняя сказка»: ее посетили многие 03.03.2026 Общество -
В Астрахани ремонт аварийного объекта культурного наследия перенесли на 2037 год 02.03.2026 Общество -
В Астраханской области ледовая обстановка помешала искать пропавшего мужчину 02.03.2026 Общество -
В Астраханской области женщина обвинила полицейского в изнасиловании 01.03.2026 Происшествия -
В Астраханской области заметно упали продажи алкоголя 25.02.2026 Общество -
Под Астраханью отец и сын провалились под лед: один из них погиб 19.02.2026 Происшествия -
Астраханцам запретили массовый выход на Варвациевский канал и Лебединое озеро 16.02.2026 Общество -
В Астрахани презентуют книгу о войне на основе рассекреченных документов 14.02.2026 Общество -
«Три капитана» приводят и уводят корабли из астраханских морских портов 12.02.2026 Общество -
Жителя Кемеровской области, убившего астраханку, нашли по отпечатку пальца 09.02.2026 Происшествия -
В Астрахани спасли семерых рыбаков, застрявших на дрейфующей льдине 09.02.2026 Общество -
В Астрахани проводится проверка по факту падения ребенка из окна 08.02.2026 Происшествия -
Эксперты выяснили, сколько бензина могут купить астраханцы за месяц 04.02.2026 АВТО -
Астраханские коммунальщики готовятся к очередной порции снега и льда 03.02.2026 Общество -
Астраханские ученые получат 63 миллиона рублей на исследование опасных инфекций 02.02.2026 Здоровье -
Астраханцам рекомендовали не выходить на лед и не пускать на него детей 02.02.2026 Общество -
Астраханские рыбаки продолжают испытывать судьбу на тонком льду 29.01.2026 Общество -
Астраханскому медицинскому колледжу обновили «сердце» 29.01.2026 Здоровье -
Мошенники обманывают астраханцев, недовольных уборкой снега 28.01.2026 Общество